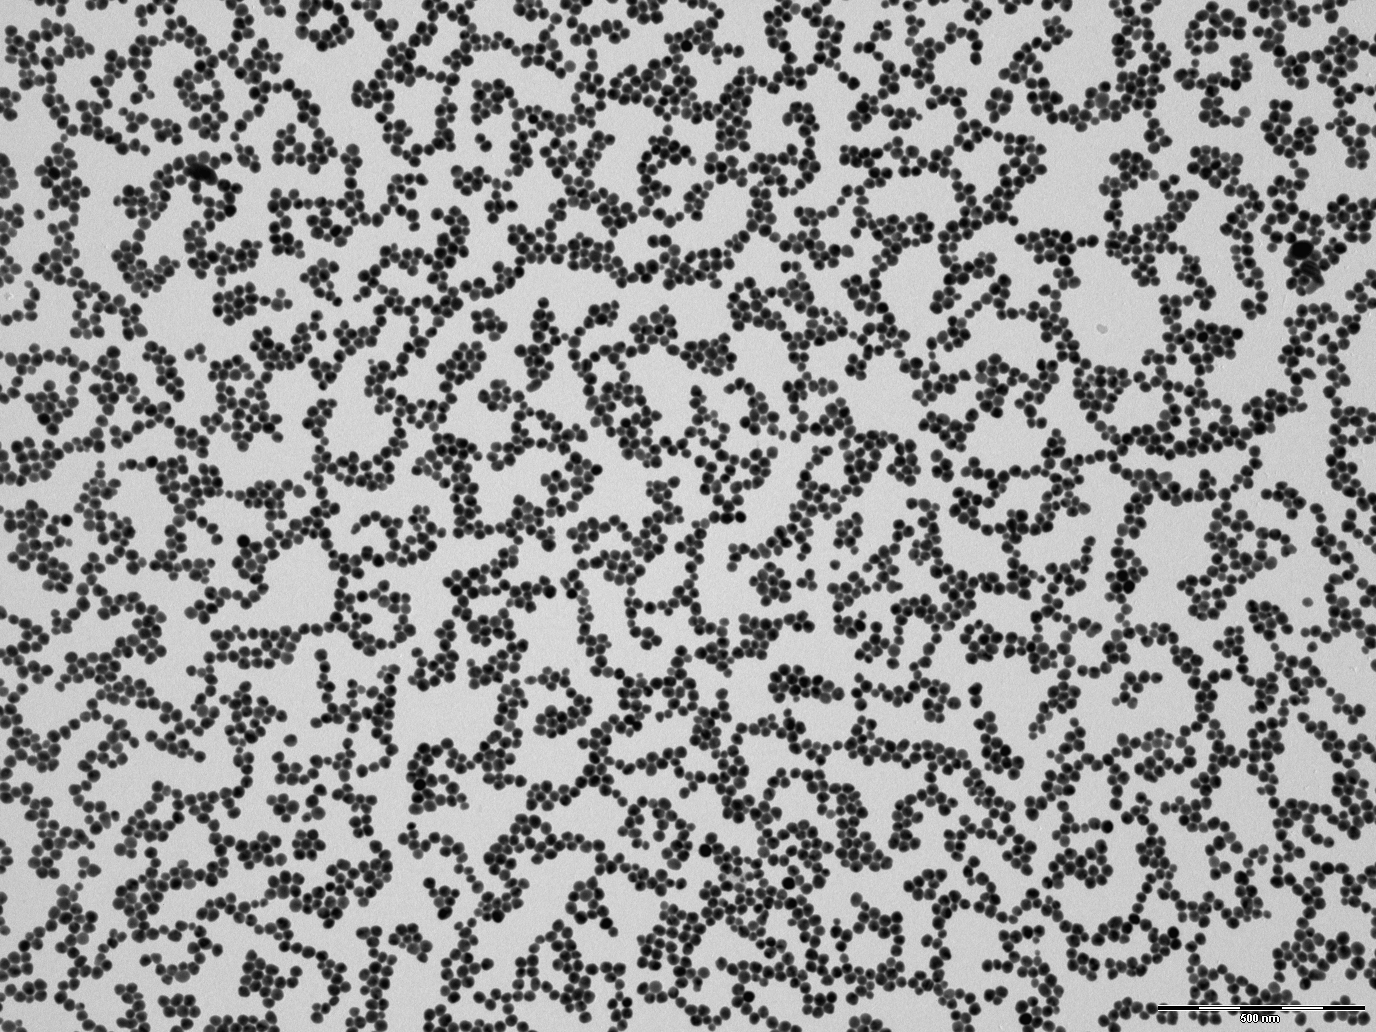

https://www.appliednanoparticles.eu
Enabling good science using high quality nanoparticles at affordable prices - Nanoparticles SL, a nanotechnology engineering company. Offered services: Consulting and Engineering, Design and supplying of Nanoparticles Colloids at best prices and Education and Training activities.
Category: Science
Platform: Custom Cart
Technologies used: Cloudfront CDN
Contact page: https://www.appliednanoparticles.eu/contact-us
Signup for Free. No Credit Card required.Suitable for marketing agencies, app developers and new business ideas.
No credit card required.